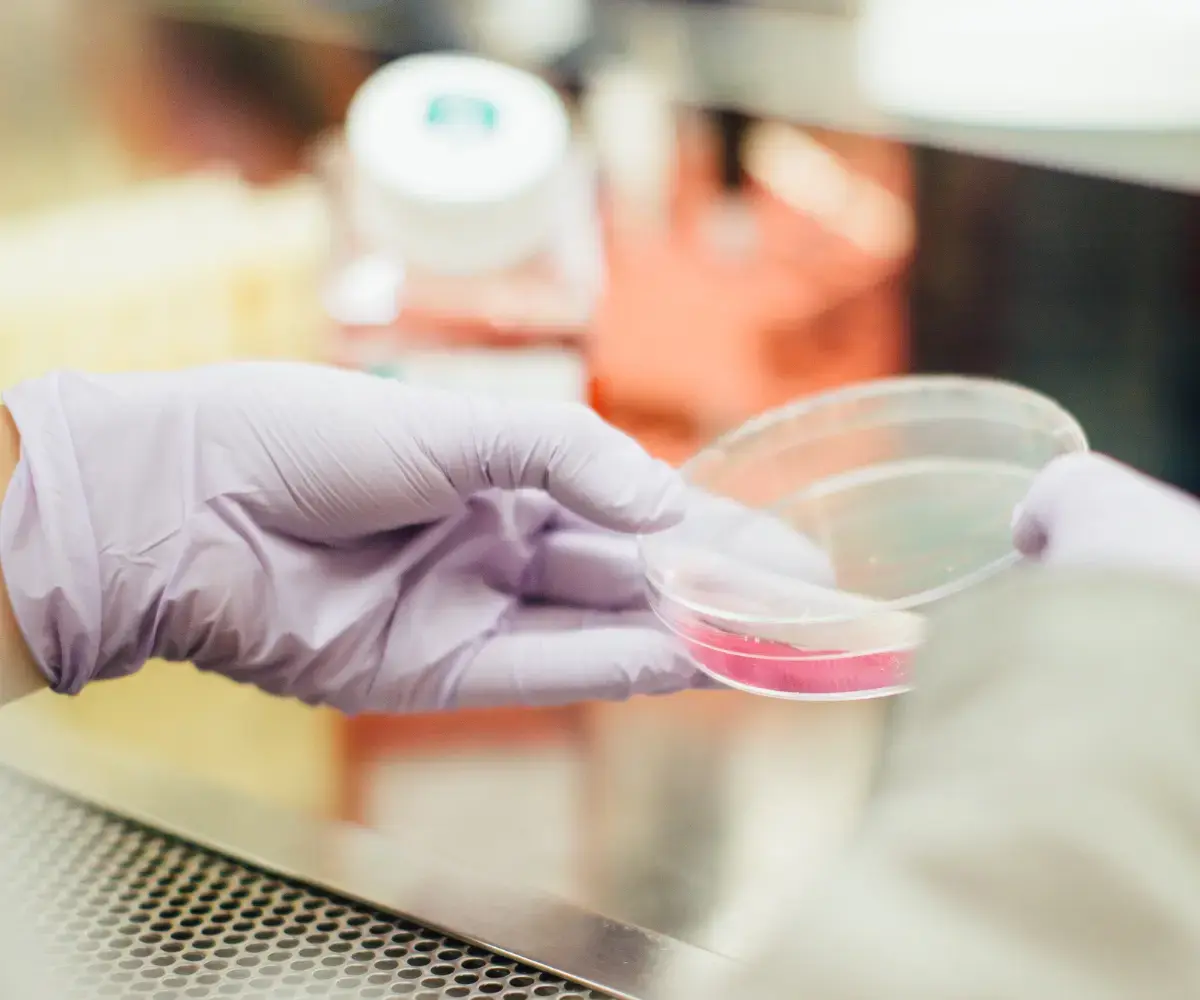

This is Wales – Key Sectors
Small country, big ambition - where Wales’s 9 key sectors truly showcase the epitome of excellence.

Key Growth Sectors in Wales
Wales – once known as the home of coal and steel, is now a thriving home to the creative industry and semiconductors. Small country, big ambition - where Wales’s 9 key sectors truly showcase the epitome of excellence.
As home to Europe’s leading compound semiconductor cluster which manufacture the constituents for electric vehicles, 5G communications and smartphones – this innovative cutting edge technology means that in your smartphone there is likely to be a little ‘piece’ of Wales!

Advanced Manufacturing
Wales has a rich industrial heritage which has evolved into a vibrant Advanced Manufacturing Sector. Home to 5,000 manufacturing companies who employ 150,000 people across aerospace, automotive, power generation and low-carbon sectors, this sector exports world-class products on a global scale.
Home to international companies such as Airbus, Toyota and IQE and a network of strong, innovative SMEs, this sector has strong links with universities and research institutions and continues to drive productivity, exports and regional growth.
With the integration of AI, this dynamic sector continues to lead the way in innovative, precision-driven manufacturing, deliver world-class products and be at the forefront of automation and cutting edge technology.
This is Wales: Engineered for Success

Clean Energy
This is Wales: A Nation invested in Clean Energy
As a world leader in Marine and Renewable Energy which is a thriving £4.8bn low-carbon economy, Wales certainly punches above its weight in driving growth in its extensive renewable energy projects.
Our country is at the forefront of advancing renewable energy, which is epitomised by incredible initiatives such as Morlais, the largest approved tidal energy site in Europe. This encompasses 35km2 of the Welsh sea bed and is projected to generate up to 240MW of low carbon energy.
In addition, Wales’s Gwynt y Môr Offshore Wind Farm in the Irish Sea produces 576MW of clean power for 400,000 homes. By leveraging its unique abundant natural resources, Wales continues to develop a strong, strategic, sustainable infrastructure whilst continuing to maintain its position as an influential innovator and world-leader in clean energy.

Compound Semiconductors
This is Wales: Fuelling the next Global Tech Revolution
With more than four decades of expertise and home to the world’s first and only dedicated compound semiconductor cluster, CSconnected, South Wales is at the heart of groundbreaking research, innovation, design and manufacturing in this multi-billion dollar international market.
Often described as being at the heart of the new industrial revolution, compound semiconductors are an integral part of advanced technologies that play a part in our everyday lives. These modern materials are integral constituents for electric vehicles, 5G communications and smartphones. Thanks to this innovative cutting edge technology, it is highly likely that your smartphone contains a little ‘piece’ of Wales!

Cyber Security
This is Wales: Where Cyber Resilience meets Practical Innovation
As a UK Leader in cyber excellence, Wales is at the hub of innovation and expertise. This growing sector works hand-in-hand with the National Cyber Security Centre and the Ministry of Defence. There are over 40,000 tech professionals specialising in this sector who are at the forefront of developing advanced digital security solutions - from threat intelligence and risk management to secure software and cloud technologies.
The Universities of Cardiff, Swansea and South Wales are accredited Centres of Excellence and are responsible for delivering pioneering cyber security courses. This close collaboration between academia, industry and government is a true success story which has created a thriving environment for the development of this important, innovative cyber ecosystem.

Fintech
This is Wales: A hub for Fintech Innovation
Fintech is short for financial technology and is the technology that is used to improve financial services. It includes on-line banking, mobile payment apps and investment platforms with the objective of enabling individuals and businesses to manage their finances more efficiently.
Wales’s digital expertise across the key sectors is a vibrant ecosystem of agility, innovation and partnership. Our thriving Fintech cluster, spearheaded by Fintech Wales, focusses on collaboration and connecting financial investors and institution with start-ups. Wales knows all about start-ups as according to the Business Growth Index, Cardiff is the number one UK city for start-up growth!
Life Sciences
This is Wales: Where Life Sciences Scale Faster
Led by the dedicated Life Sciences Hub, Wales’s Life Sciences Sector nurtures close collaboration between the NHS, academia and industry. Home to 300 companies employing over 13,000 people and generating a turnover of £3.59 billion, this sector benefits from eight leading universities, three medical schools and an entrepreneurial, forward-thinking industry base.
This highly connected ecosystem is at the forefront of innovation in Cell Therapy, Diagnostics, MedTech, Regenerative Medicine and Wound Healing. Ongoing collaboration between stem cell research centres, oncology biobanks, All Wales Gene Park, Genomics Partnership Wales and the NHS enable abundant research opportunities and partnerships to drive the continuing development of transformative products for global markets.

Creative Industries
This is Wales: Where Creativity takes Centre Stage
Encompassing Film and TV, Music, Games, Animation and Publishing, Wales truly flourishes in this exciting key sector – over 35,000 people are employed in the creative industries generating a turnover of £1.5 billion.
From well-loved TV programmes such as Gavin & Stacey and Dr Who, to iconic shows such as Sex Education and The Crown, and global blockbusters such as the Clash of the Titans and Harry Potter and the Deathly Hallows, Wales’s cinematic coastlines, craggy mountains, historic castles, cityscapes and beautiful rural villages have been proud to take a starring role.
The Games industry is thriving – from next generation AI projects to video gaming tournaments, this sector is all about innovation and pushing the boundaries on technology. Animation has enjoyed worldwide success with SuperTed and Rastamouse and more recently, Dave Spud and Cyw.
Wales has an amazing array of musical talent all supported by outstanding venues, festivals, promoters, studios and record labels. Together with a commitment to develop music at grass roots level, Wales will always be known as the ‘Land of Song’.

Food & Drink
This is Wales: Where Makers, Growers and Producers thrive and where Provenance meets Passion
Wales is renowned for its rich Welsh larder nurtured by a land of lush green pastures, majestic mountains, tranquil lakes and our bountiful sea, teeming with a rich variety of sea life. This sector is a cornerstone of the Welsh Economy, supporting over 40,000 jobs, combining traditional craftmanship with innovation, and a renowned focus on provenance, sustainability and traceability.
From tender Saltmarsh Welsh lamb, artisan seafood, traditional Welsh dishes such as Cawl, Barra Brith and Welsh cakes to premium handcrafted gins, a thriving craft beer scene and the verdant vineyards of the emerging award-wining Welsh wine industry, Wales is proud of its success at home and abroad - currently worth £850 million in exports.

Tourism
This is Wales: Where Adventure comes Naturally and Memories are made
Welsh Tourism is a vibrant and growing industry worth over £5 billion - our country has four UNESCO World Heritage Sites, three National Parks, five Areas of Outstanding Natural Beauty, an award-winning 1,400km coastal path and more castles per square km than anywhere else in Europe. From the rugged mountain of Snowdonia and the Brecon Beacons to the stunning coastlines of Pembrokeshire and the Gower Peninsula, Wales offers adventure, relaxation and exploration for everyone.
Supporting a total of 149,000 jobs, this important sector contributes billions of pounds to the Welsh economy which in turn supports community regeneration and international recognition as Wales’s profile on the Global stage continues to expand.






